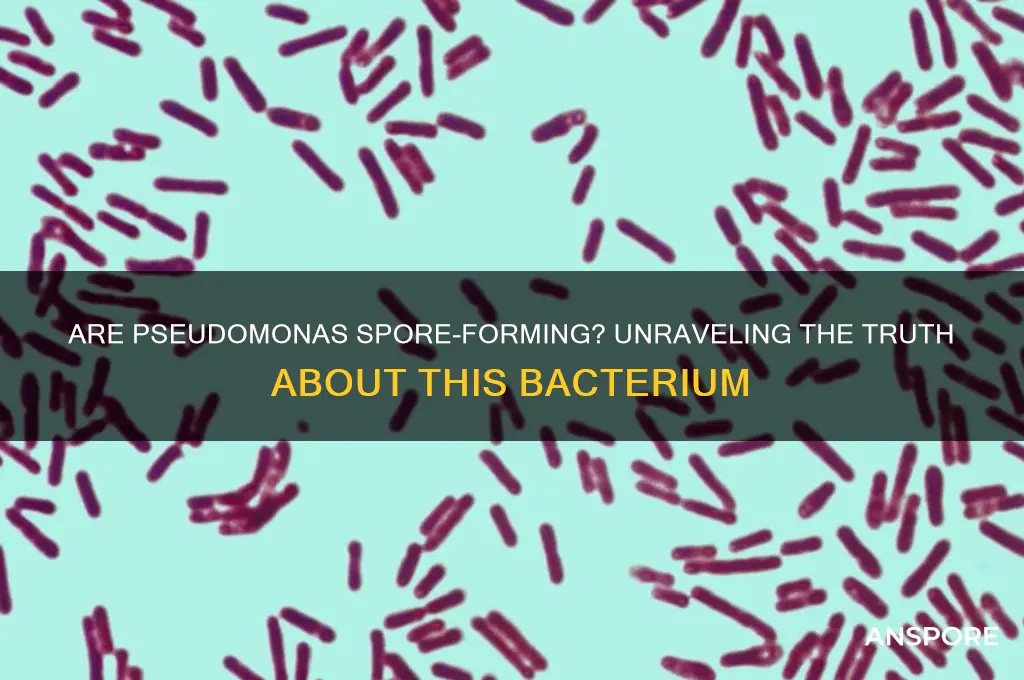
are pseudomonas spore forming

Pseudomonas, a genus of Gram-negative bacteria, is widely recognized for its versatility and adaptability in various environments, ranging from soil and water to clinical settings. One common question regarding these bacteria is whether they are spore-forming. Unlike spore-forming bacteria such as *Bacillus* or *Clostridium*, Pseudomonas species do not produce spores as a means of survival under harsh conditions. Instead, they rely on their robust metabolic capabilities and biofilm formation to endure adverse environments. This distinction is crucial in understanding their behavior, particularly in medical and industrial contexts, where their persistence and resistance to antimicrobials pose significant challenges.
Explore related products
What You'll Learn

Pseudomonas aeruginosa spore formation
Pseudomonas aeruginosa, a ubiquitous Gram-negative bacterium, is notorious for its resilience in diverse environments and its role in hospital-acquired infections. Despite its adaptability, P. aeruginosa does not form spores. This distinction is critical, as spore formation is a survival mechanism employed by certain bacteria, such as *Bacillus* and *Clostridium*, to withstand extreme conditions like desiccation, heat, and antibiotics. Spores are highly resistant structures that allow bacteria to persist in dormant states for years, posing significant challenges in infection control and treatment. In contrast, *P. aeruginosa* relies on other strategies, such as biofilm formation and intrinsic antibiotic resistance, to survive harsh conditions. Understanding this difference is essential for clinicians and researchers, as it influences disinfection protocols, treatment approaches, and the development of targeted therapies.
Analyzing the biology of *P. aeruginosa* reveals why spore formation is absent in this species. Unlike spore-forming bacteria, which undergo a complex process of sporulation involving the formation of an endospore within a vegetative cell, *P. aeruginosa* lacks the genetic machinery required for this process. Spore formation is governed by specific genes, such as those in the *spo* operon in *Bacillus subtilis*, which are absent in the *P. aeruginosa* genome. Instead, *P. aeruginosa* employs alternative survival mechanisms, such as producing extracellular polymeric substances (EPS) to form biofilms, which protect the bacteria from environmental stressors and antimicrobial agents. While biofilms are less resilient than spores, they are highly effective in clinical settings, contributing to the persistence of *P. aeruginosa* in medical devices and hospital surfaces.
From a practical standpoint, the absence of spore formation in *P. aeruginosa* has significant implications for infection control. Standard disinfection methods, such as alcohol-based sanitizers and quaternary ammonium compounds, are generally effective against non-spore-forming bacteria like *P. aeruginosa*. However, the bacterium’s ability to form biofilms necessitates more rigorous cleaning protocols, particularly in healthcare settings. For example, medical equipment contaminated with *P. aeruginosa* biofilms may require treatment with high-level disinfectants, such as hydrogen peroxide or glutaraldehyde, to ensure complete eradication. Additionally, patients with cystic fibrosis, who are particularly susceptible to chronic *P. aeruginosa* infections, benefit from proactive measures like airway clearance techniques and inhaled antibiotics to prevent biofilm establishment.
Comparatively, the lack of spore formation in *P. aeruginosa* highlights the diversity of bacterial survival strategies. While spore-forming bacteria like *Clostridioides difficile* pose challenges due to their ability to persist in the environment for extended periods, *P. aeruginosa* presents a different threat through its rapid adaptation and biofilm-mediated resistance. For instance, *C. difficile* spores can survive on surfaces for months, necessitating spore-specific disinfectants like chlorine-based cleaners. In contrast, *P. aeruginosa* requires targeted interventions to disrupt biofilms, such as the use of enzymes like DNase or antimicrobial peptides. This comparison underscores the importance of tailoring infection control strategies to the specific survival mechanisms of each pathogen.
In conclusion, while *P. aeruginosa* is a formidable pathogen, its inability to form spores simplifies certain aspects of its management. Clinicians and researchers can focus on combating its biofilm-forming capabilities and intrinsic resistance mechanisms rather than addressing the extreme resilience of spores. However, this does not diminish the urgency of controlling *P. aeruginosa* infections, particularly in vulnerable populations. By understanding its unique biology and survival strategies, healthcare providers can implement effective measures to prevent and treat infections, ultimately improving patient outcomes and reducing the burden of this pervasive bacterium.
Are Fungal Spores Haploid? Unraveling the Genetics of Fungi
You may want to see also

Spore-forming bacteria vs. Pseudomonas
Pseudomonas species are not spore-forming bacteria, a fact that distinguishes them from some of the most resilient microorganisms on Earth. Spore formation is a survival mechanism employed by certain bacteria, such as *Bacillus* and *Clostridium*, to endure harsh environmental conditions like extreme temperatures, desiccation, and exposure to chemicals. These spores are highly resistant structures that can remain dormant for years, reactivating when conditions become favorable. In contrast, Pseudomonas, a genus of Gram-negative bacteria, relies on other strategies for survival, such as biofilm formation and metabolic versatility, but lacks the ability to produce spores.
Understanding this difference is crucial in clinical and industrial settings. For instance, spore-forming bacteria like *Clostridium difficile* pose significant challenges in healthcare due to their ability to persist on surfaces and resist disinfection. Infections caused by these bacteria often require aggressive treatment, including specific antibiotics like vancomycin or fidaxomicin, and stringent infection control measures. Pseudomonas, on the other hand, is notorious for its intrinsic resistance to many antibiotics and its ability to colonize medical devices, such as catheters and ventilators. While Pseudomonas infections are treated with antibiotics like piperacillin-tazobactam or ceftazidime, their prevention hinges on controlling biofilm formation rather than addressing spore contamination.
From a practical standpoint, the absence of spore formation in Pseudomonas simplifies certain disinfection protocols. For example, in laboratory or industrial settings, autoclaving at 121°C for 15–20 minutes effectively kills vegetative cells of Pseudomonas but is necessary to eliminate spores of bacteria like *Bacillus anthracis*. However, Pseudomonas’s ability to survive in diverse environments, including water and soil, means that routine disinfection must still target its biofilm-forming capabilities. Using biocides like chlorine or quaternary ammonium compounds can disrupt Pseudomonas biofilms, but their efficacy varies depending on concentration and contact time.
Comparatively, the resilience of spore-forming bacteria necessitates more rigorous decontamination methods. Spores can withstand boiling water, most disinfectants, and even some sterilizing agents, requiring specialized procedures like autoclaving under steam at high pressure. This distinction highlights why Pseudomonas, despite its own challenges, is less problematic in terms of environmental persistence. However, its rapid growth and adaptability make it a persistent threat in healthcare and food production, where it can contaminate products like milk or pharmaceuticals, leading to spoilage or infection.
In summary, while spore-forming bacteria and Pseudomonas both present unique challenges, their survival mechanisms differ fundamentally. Spore formation allows certain bacteria to endure extreme conditions, demanding aggressive eradication methods, whereas Pseudomonas relies on biofilm formation and metabolic flexibility. Recognizing these differences enables tailored strategies for control and treatment, ensuring effective management of these microorganisms in various contexts.
Are Spore-Grown Plants Harmful? Unveiling the Truth About Their Safety
You may want to see also

Pseudomonas survival mechanisms
Pseudomonas species are renowned for their resilience, thriving in diverse environments from soil to hospitals. Unlike spore-forming bacteria such as Bacillus or Clostridium, Pseudomonas does not produce spores. Instead, it employs a sophisticated arsenal of survival mechanisms to endure harsh conditions, including desiccation, nutrient deprivation, and antimicrobial exposure. Understanding these strategies is crucial for combating Pseudomonas infections, particularly in clinical settings where it is a leading cause of nosocomial infections.
One key survival mechanism is biofilm formation. Pseudomonas bacteria secrete extracellular polymeric substances (EPS) that form a protective matrix, shielding them from antibiotics, host immune responses, and environmental stressors. Biofilms can develop on medical devices like catheters and ventilators, making infections difficult to treat. To disrupt biofilms, clinicians often use a combination of enzymes (e.g., DNase to degrade EPS DNA) and high-dose antibiotics (e.g., 20 mg/kg of tobramycin for cystic fibrosis patients). Regular cleaning and replacement of medical devices are also essential preventive measures.
Another survival tactic is metabolic versatility. Pseudomonas can utilize a wide range of carbon sources, from simple sugars to aromatic compounds, allowing it to persist in nutrient-poor environments. For instance, in water pipes or soil, it can switch to a slow-growing, energy-conserving state, reducing its susceptibility to antibiotics. In industrial settings, controlling Pseudomonas growth requires rigorous disinfection protocols, such as using 100–200 ppm of chlorine or periodic flushing of water systems to limit nutrient accumulation.
Pseudomonas also possesses efflux pumps, protein systems that expel antibiotics and other toxins from the cell. These pumps contribute to multidrug resistance, a significant challenge in treating infections. Inhibiting efflux pumps with adjunctive therapies, such as phenylalanine-arginine β-naphthylamide (PAβN), can enhance antibiotic efficacy. However, clinical use of efflux pump inhibitors remains experimental, and their safety profiles are still under investigation.
Finally, Pseudomonas exhibits phenotypic heterogeneity, with subpopulations of cells entering a dormant, persister state. These persister cells are less metabolically active and highly tolerant to antibiotics, serving as a reservoir for relapse. Targeting persisters requires novel approaches, such as using antimicrobial peptides or metabolic inhibitors. For example, combining antibiotics with A22, a drug that inhibits cell division, has shown promise in eradicating persister cells in laboratory studies.
In summary, while Pseudomonas does not form spores, its survival mechanisms—biofilm formation, metabolic adaptability, efflux pumps, and persister cells—make it a formidable pathogen. Combating Pseudomonas infections demands a multifaceted approach, combining antimicrobial therapy with environmental control measures and innovative strategies to target its resilience mechanisms.
Morning Glories: Seeds or Spores? Unraveling the Botanical Mystery
You may want to see also
Explore related products
$24.89 $26.99

Endospore formation in Pseudomonas
Pseudomonas, a genus of Gram-negative bacteria, is widely recognized for its metabolic versatility and environmental resilience. However, one question often arises: do Pseudomonas species form endospores? The short answer is no. Unlike spore-forming bacteria such as Bacillus and Clostridium, Pseudomonas lacks the genetic machinery required for endospore formation. Endospores are highly resistant structures that allow certain bacteria to survive extreme conditions, but Pseudomonas relies on other mechanisms, such as biofilm formation and metabolic adaptability, to endure harsh environments.
To understand why Pseudomonas does not form endospores, consider the biological processes involved. Endospore formation is a complex, multi-stage process requiring specific genes and regulatory pathways. Pseudomonas species lack the key sporulation genes, such as those in the *spo* operon, which are essential for endospore development. Instead, Pseudomonas has evolved alternative survival strategies, such as producing extracellular polymers to form biofilms, which protect cells from desiccation, antibiotics, and predators. This distinction highlights the diverse ways bacteria adapt to environmental challenges.
From a practical standpoint, the absence of endospore formation in Pseudomonas has significant implications in industries like healthcare and food safety. For instance, while Pseudomonas can contaminate medical devices and food products, it does not pose the same long-term persistence risks as spore-forming bacteria. In healthcare settings, disinfectants effective against vegetative cells (e.g., 70% ethanol or quaternary ammonium compounds) are sufficient to control Pseudomonas. However, in food processing, preventing biofilm formation on surfaces is critical, as biofilms can harbor Pseudomonas and lead to spoilage or infection.
Comparatively, the inability of Pseudomonas to form endospores also influences its role in environmental ecosystems. While spore-forming bacteria can remain dormant for years, Pseudomonas must actively metabolize to survive. This makes it more susceptible to environmental changes but also more responsive to nutrient availability. For example, in soil or water systems, Pseudomonas can rapidly colonize organic matter, outcompeting slower-growing organisms. This dynamic behavior underscores its importance in nutrient cycling and bioremediation processes.
In conclusion, while Pseudomonas does not form endospores, its survival strategies are no less remarkable. Understanding this distinction is crucial for effective management in clinical, industrial, and environmental contexts. By focusing on biofilm prevention and targeting its metabolic vulnerabilities, we can mitigate the risks associated with Pseudomonas contamination. This knowledge not only clarifies a common misconception but also highlights the ingenuity of bacterial adaptation in the absence of endospore formation.
Understanding Plant Spores: Tiny Survival Units and Their Role in Reproduction
You may want to see also

Pseudomonas resistance without spores
Pseudomonas aeruginosa, a notorious pathogen, lacks the ability to form spores, yet it exhibits remarkable resistance to various environmental stresses and antimicrobial agents. This resistance is not dependent on spore formation but rather on a complex array of mechanisms that allow it to survive and thrive in diverse settings, from hospital wards to natural water systems. Understanding these mechanisms is crucial for developing effective strategies to combat Pseudomonas infections, which are increasingly challenging to treat due to their inherent and acquired resistance.
One key mechanism contributing to Pseudomonas resistance is its robust outer membrane, which acts as a selective barrier against many antibiotics. This membrane is composed of lipopolysaccharides and proteins that restrict the entry of hydrophobic and large molecules. For instance, the expression of efflux pumps, such as the MexAB-OprM system, actively expels antibiotics like fluoroquinolones and beta-lactams, reducing their intracellular concentration. Clinically, this means that standard antibiotic dosages may be ineffective, necessitating higher doses or combination therapies. For example, in treating severe Pseudomonas infections in adults, a combination of meropenem (2 g every 8 hours) and tobramycin (7 mg/kg/day) is often employed to bypass these resistance mechanisms.
Another critical factor is biofilm formation, a communal lifestyle where Pseudomonas cells embed themselves in a self-produced extracellular matrix. Biofilms can increase resistance to antibiotics by up to 1,000-fold compared to planktonic cells. This is partly due to the physical barrier of the matrix and the slow growth rate of cells within the biofilm, which makes them less susceptible to antibiotics targeting active processes. Disrupting biofilms requires innovative approaches, such as using enzymes like DNase to degrade the extracellular DNA component of the matrix or employing antimicrobial peptides that can penetrate biofilms more effectively.
Genetic adaptability further enhances Pseudomonas resistance. Through mutations and horizontal gene transfer, Pseudomonas can acquire resistance genes, such as those encoding extended-spectrum beta-lactamases (ESBLs) or carbapenemases. These enzymes inactivate a wide range of antibiotics, rendering them ineffective. For instance, the presence of the *bla*VIM gene confers resistance to carbapenems, a last-resort antibiotic class. Monitoring for such resistance genes in clinical isolates is essential for guiding appropriate treatment, often involving newer antibiotics like ceftolozane-tazobactam or combinations of older agents with proven efficacy.
Practical strategies to mitigate Pseudomonas resistance include strict infection control measures, such as hand hygiene and environmental disinfection, to prevent transmission. In healthcare settings, isolating patients with Pseudomonas infections and using dedicated equipment can limit spread. For individuals at home, particularly those with cystic fibrosis or chronic wounds, regular cleaning of medical devices and surfaces is vital. Additionally, antimicrobial stewardship programs play a pivotal role in optimizing antibiotic use, reducing selective pressure, and preserving the efficacy of available agents. By addressing resistance through these multifaceted approaches, we can better manage Pseudomonas infections despite their lack of spore formation.
Unveiling the Survival Secrets: How Spores Work and Thrive
You may want to see also
Frequently asked questions
No, Pseudomonas bacteria are not spore-forming. They are Gram-negative, rod-shaped bacteria that reproduce through binary fission and do not produce spores as a survival mechanism.
Yes, Pseudomonas can survive in harsh conditions due to their ability to form biofilms, produce protective extracellular polymers, and adapt to a wide range of environments, but they do not form spores.
Pseudomonas bacteria are highly resilient and can survive in diverse environments, similar to some spore-forming bacteria. However, their survival mechanisms do not include spore formation, which is a key distinction.
No, none of the known strains of Pseudomonas produce spores. Their survival strategies rely on other mechanisms, such as biofilm formation and metabolic versatility, rather than spore formation.































